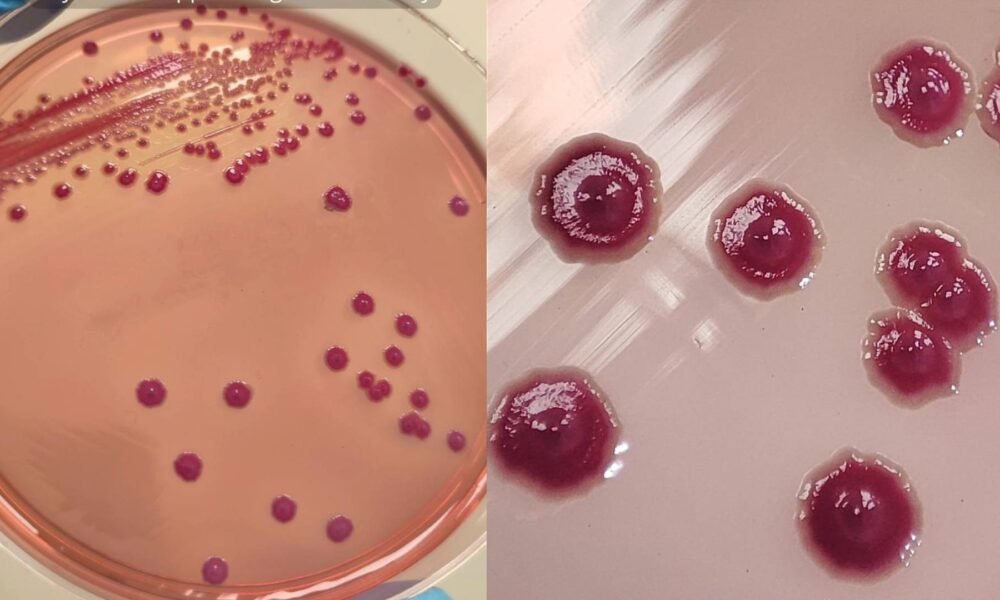
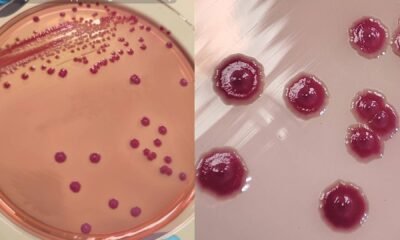
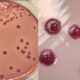

Na última quinta-feira (19), Dia de São José, 67 municípios da Paraíba registraram precipitações, conforme dados da Agência Executiva de Gestão das Águas da Paraíba (Aesa)....



Acidente grave ocorreu na rodovia RN-117, entre Olho d’Água do Borges e Caraúbas. Um homem morreu e outro ficou ferido após uma batida frontal entre um...



Presidente cobra responsabilidade dos cinco membros permanentes diante do conflito Em discurso no Sindicato dos Metalúrgicos de São Bernardo do Campo, o presidente Luiz Inácio Lula...



Encontro vai debater o futuro do planejamento urbano e rural da cidade nesta sexta-feira A Câmara Municipal de Mossoró promove nesta sexta-feira (20), a partir das...



Deputados estaduais e federais têm até o dia 3 de abril para trocar de partido sem perder o mandato, aproveitando a janela partidária prevista na legislação...

Surto que matou 15 bebês revelou que Phytobacter diazotrophicus ainda é confundida em exames laboratoriais. Em 2013, um surto de sepse atingiu 65 recém-nascidos em quatro...



Duas crianças de 9 e 11 anos não resistiram às chamas em apartamento na Zona Oeste da capital pernambucana. Rodrigo Magalhães de Lira Júnior, 11 anos,...



Um agricultor de Patrocínio, Minas Gerais, ficou surpreso ao encontrar pequenos frutos verdes parecidos com tomates em sua plantação de batata. Esse fenômeno, apesar de raro...



Ação nacional foca na saúde da mulher e ocorre neste sábado em três unidades do estado. Os hospitais universitários do Rio Grande do Norte vão realizar...



Jogadora foi premiada pela Confederação Brasileira do Desporto Universitário em Brasília Bella Souza, natural de Mossoró e residente em Manibú (CE), foi reconhecida como a melhor...